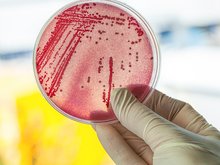

PRESSEMITTEILUNGEN & AKTUELLES
Ausgewählte Kategorie: Landwirtschaft
TERMINE
LAG Wissenschafts-, Hochschul- und Technologiepolitik
Onlinetreffen der LAG. Für Fragen und mehr Infos wende dich gern an die Sprecher*innen via lag.wht@gruene-brandenburg.de
MehrLAG Mobilität
Bei Interesse bitte bei den Sprecher*innen melden unter: lag.mobilitaet@gruene-brandenburg.de
Mehr